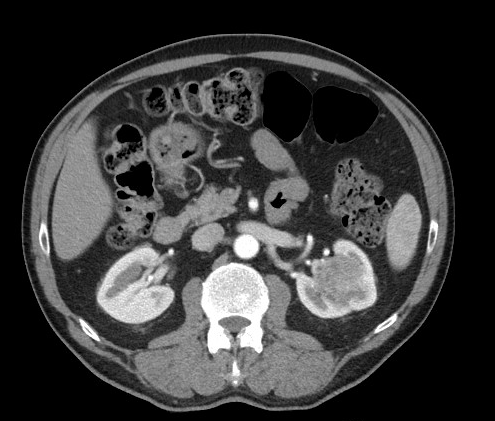

5, 6 y 7 de febrero de 2026
Enfoque individual
Hombre de 55 años con AP DM, DLP, en tto con oxicodona por hernias discales lumbares. AF de padre con carcinoma renal. Refiere dolor lumbar izquierdo de 5 días de evolución, irradiado a ingle, de tipo cólico que empeora en decúbito. Inicialmente disuria ya resuelta sin hematuria. Afebril.
EF: BEG. No apofisalgias o dolor en musculatura paravertebral lumbar. Abdomen blando, depresible, doloroso a la palpación profunda en flanco izquierdo e ingle izquierda, sin defensa o signos de irritación peritoneal. Murphy y Blumberg negativos. PPR izquierda dudosa. Ante clínica de dolor lumbar y sd miccional se decide hacer eco para valorar posible CRU izquierdo.
Hallazgos ecográficos
Riñones sin datos de hidronefrosis o litiasis pero en riñón izdo se visualiza lesión levemente hipoecogénica respecto a médula renal, de bordes bien definidos con doppler positivo en periferia.
Pruebas complementarias
No.
Juicio clínico, diagnóstico diferencial, concordancia con el hospital (en su caso)
LOE renal a estudio.
Tratamiento, planes de actuación
Se realiza e-consulta a servicio de Urología adjuntando imágenes para valoración más rápida y en 24 h Urología capta al paciente para CT abdominal con contraste y revisión en consultas de alta resolución.
Evolución
CT: masa renal izquierda, solida, ligeramente heterogénea de aproximadamente 39 x 36 x 27 mm, localizada fundamentalmente en seno renal de polo superior con pequeña afectación de la cortical. No adenopatías patológicas. No trombosis de vena renal ni alteraciones anatómicas vasculares. Ante estos hallazgos se propone tratamiento quirúrgico con nefectomía total.
La ecografía clínica se está convirtiendo en una herramienta cada vez más accesible en nuestras consultas que nos brinda un gran apoyo a la hora de completar una exploración del paciente y puede suponer una gran ayuda para tomar decisiones más agilizadas y de alto impacto para nuestros pacientes.